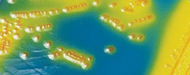

Microbiology
HiMedia has developed their own technology and stands among the world’s handful of companies possessing the high-tech knowhow for manufacturing microbiological culture media. HiMedia offers a very broad range of media formulations; standard media and customer specified media in dehydrated form for use in different fields; clinical, food, environment, cosmetic, dairy, water, pharmaceutical industries etc. This also includes media specified by various pharmacopoeias recommended for different applications as sterility testing, microbial limit tests etc.